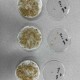

이번 행사는 KBS 광주방송 주관으로 열렸으며 김영록 전라남도지사와 강기정 광주광역시장을 비롯해 전남 동부권 5개 시·군 단체장 등이 참석해 행정통합 추진 방향과 지역 현안을 공유하고 시민 의견을 청취했다.
이 자리에서 정기명 여수시장은 주력산업인 석유화학산업의 장기 불황으로 지역경제가 심각한 어려움에 직면해 있다며 산업구조 다변화와 미래 신산업 전환을 위한 국가 차원의 산업용지 공급이 시급하다고 강조했다.
여수시는 이번 건의가 행정통합 논의와 연계해 지역의 산업위기 대응, 신산업 전환을 동시에 추진하는 실행 전략으로서 의미가 크다고 보고 향후 기본구상용역과 관계기관 협의를 통해 사업 구체화에 속도를 낼 방침이다.


 2026.04.16 (목) 17:07
2026.04.16 (목) 17:07